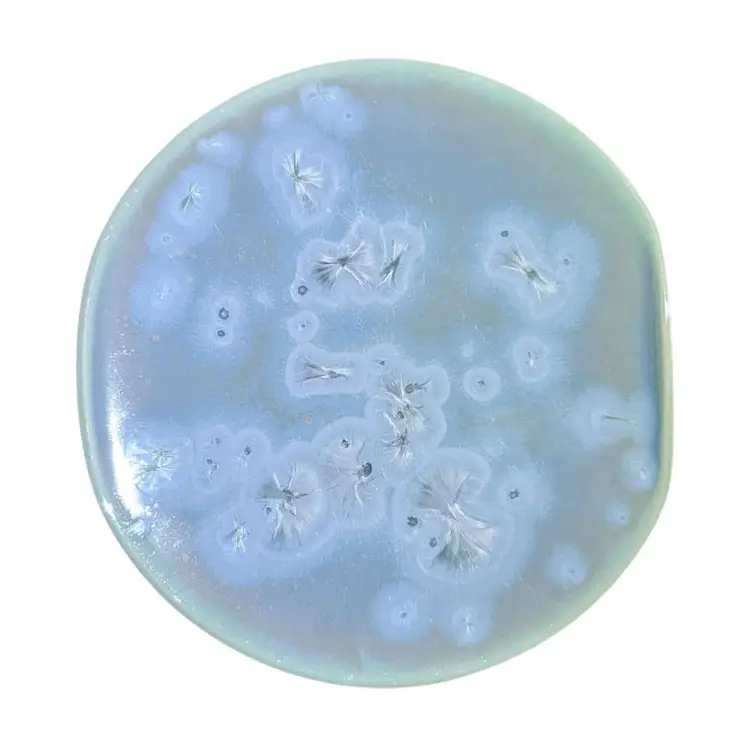
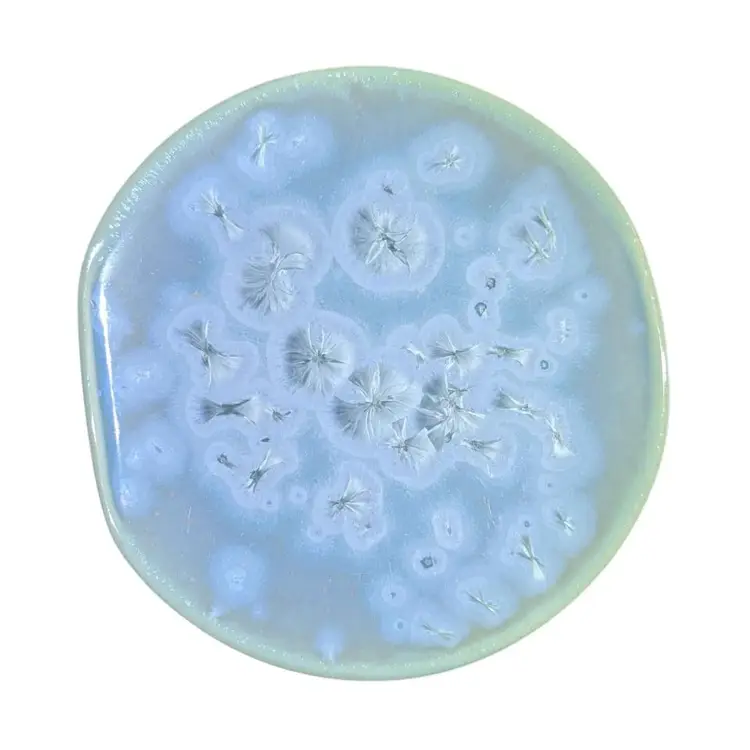
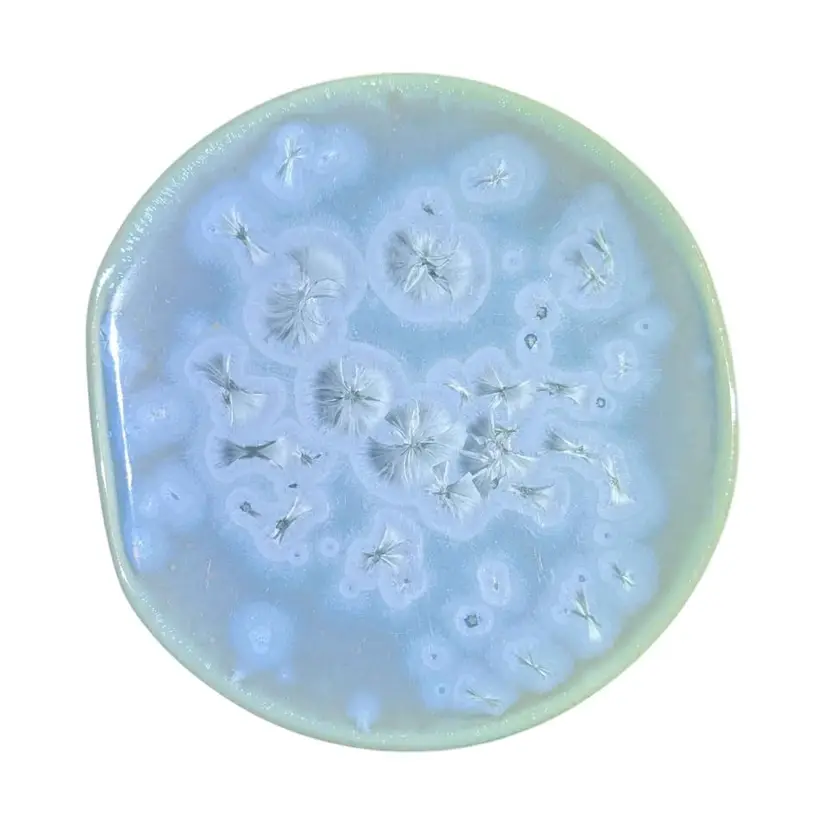
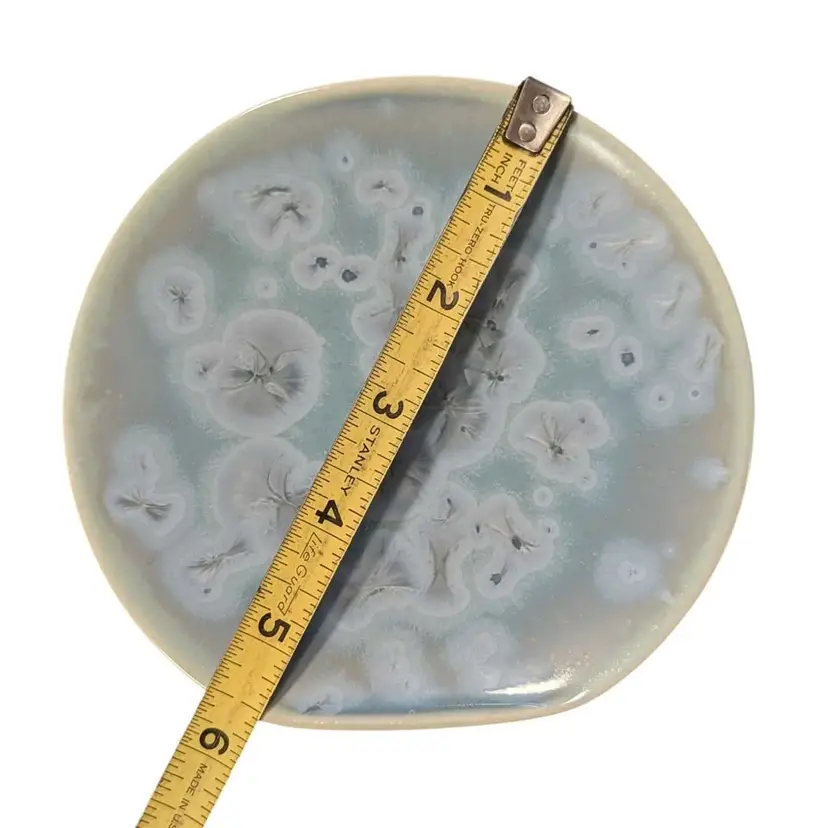

Set Of 4 Kotobuki Kyo Kiyomizu Yaki Ware Pottery Flower Crystal Plates Japan 5.5"
Details
Set Of 4 Kotobuki Kyo Kiyomizu Yaki Ware Pottery Flower Crystal Plates Japan 5.5". This set of 4 plates is absolutely gorgeous - they are all a little different but they are all the same aqua color scheme. This style of pottery and glazing makes for such unique designs - they have a metallic crystal look about them - almost like a stone or mineral and the more they move around in the light the more variations they have. These are all in excellent condition with no chips or cracks and each one has a mark in the middle of the bottom of the plate as well as a sticker marked Kotobuki Japan. Measurements are in the photos.
4 Views
Meet Your Seller
Selling since November 2023
Hello, my name is Meagan and I am from Oregon and love everything about the outdoors and array of activities that the PNW has to offer. My middle school sweetheart husband and I are in our 2nd year of living full time in our fifth wheel trailer with our Chiweenie dog and working to try and keep our mobile dream alive. I enjoy finding unique and handmade items and I'm a big fan of vintage colored glass. Photography is another hobby passion of mine and I really enjoy integrating that with posting items - I like finding unique locations & backdrops to stage the item and really show off its features! Thanks so much for taking a peek at my items and learning about me!
Report Listing
Report Listing